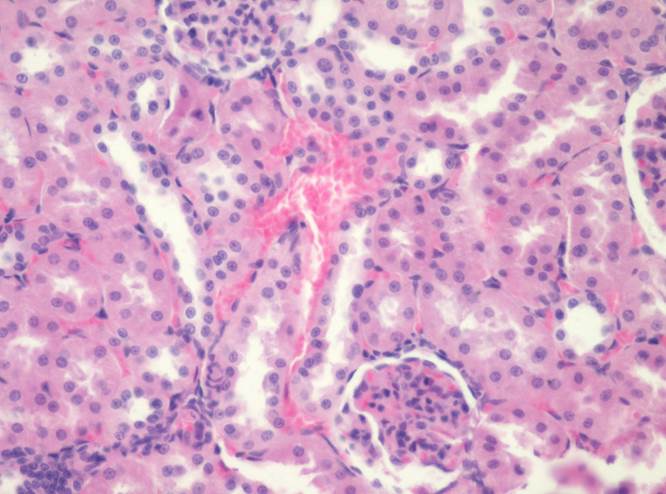

ОГП – 128
Гистологическое строение мочевых органов.
Препарат № 1. «Почка взрослого»,(окраска гематоксилином и
ОГП - 126 эозином).
- Строма почки
- соединительнотканная капсула.
- соединительнотканные прослойки
- Корковое вещество:
3. почечное тельце;
4. сосудистый клубочек;
5. наружный листок капсулы почечного тельца;
6. полость почечного тельца;
7. проксимальный извитой каналец;
8. дистальный извитой каналец.
9. собирательная трубка
III. Мозговое вещество:
10. нисходящая часть тонкого канальца;
11. восходящая часть тонкого канальца;
12. петля (Генле),
13. собирательная трубка.
I.1 II


I.2
II.3


II: 3 5 4 6
9 7 8

II: 3 4 5 6 7
Мозговое вещество: III. 13


III. 10 11
13

Препарат № 2. «Мочеточник», (окраска гематоксилином и эозином).
ОГП – 128
Слизистая оболочка:
1. переходный эпителий;
2. собственная пластинка.
II. Подслизистая оболочка.
III. Мышечная оболочка:
3. внутренний слой – продольный;
4. наружный слой – циркулярный.
IY. Адвентициальная оболочка.
5. рыхлая соединительная ткань
6. кровеносные сосуды
I.
1 2 II


III 3 4
6 II III: 3 4 IV: 5

Препарат № 3. «Мочевой пузырь», (окраска гематоксилином и эозином).